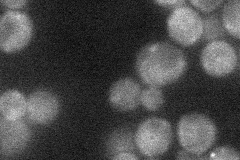
YDL035C

View description
Plasma membrane G protein coupled receptor (GPCR) that interacts with the heterotrimeric G protein alpha subunit, Gpa2p, and with Plc1p; sensor that integrates nutritional signals with the modulation of cell fate via PKA and cAMP synthesis
Localization:
Intensity:
Fold change:
Significance:
-
C’ GFP library in SD

below threshold17.97 -
N' NOP1pr-GFP in SD
punctate22.1822 -
N' TEF2pr-mCherry in SD

below threshold7.42517 -
N' NATIVEpr-GFP in SD

below threshold19.1289 -
N' TEF2pr-VC and Cyto-VN in SD

#N/A0 -
C’ GFP library in SD+DTT

cytosol17.340.96No -
C’ GFP library in SD+H2O2

cytosol18.731.04No -
C’ GFP library in Starvation Media

cytosol20.711.15No -
C’ GFP library on the background of Pup2-DaMP

below threshold -
C’ GFP library on the background of CCT mutant

below threshold16.32830.907999No
